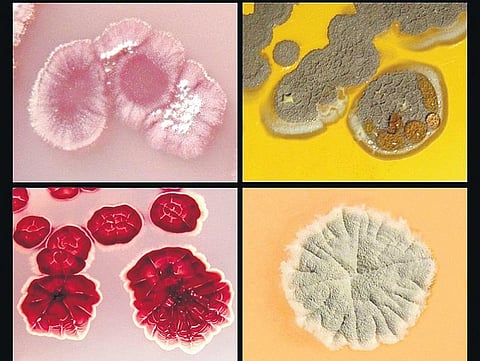
எதிலிருந்து வருகிறது மண்வாசனை?

முதல் மழைத் துளி மண்ணில் பட்டதும், சட்டென்று புறப்பட்டு வந்து நமது நாசியைத் துளைக்கும் அந்த இனிமையான நறுமணம் எப்படி வருகிறது, எங்கேயிருந்து வருகிறது?
அதை ‘மண்வாசனை' என்று சொல்லிவிடுகிறோம். ஆனால், மண்ணிலிருந்தா வருகிறது அந்த வாசனை? இல்லை.
பாக்டீரிய வித்து
மண்வாசனைக்கு ஆங்கிலத்தில் petrichor என்று பெயர். மண் மீது மழைத் துளிகள் பட்டவுடன் வேதிவினை நடப்பதால் மண்வாசனை தோன்றுகிறது.
மண்ணில் வாழும் ஆக்டினோமைசீஸ் அல்லது ஸ்டிரெப்டோமைசீஸ் என்ற பாக்டீரியாக்கள், வெளியிடும் வேதிப்பொருட்களே இனிமை யான மண்வாசனை.
இந்தப் பாக்டீரியா வகைகள் உலகம் முழுவதும் மண்ணில் இழைகளாக வாழ்கின்றன. மண் காய்ந்து போகும்போது, இவை தங்கள் வித்துகளை வெளியிடுகின்றன. மழை வரும்போது மழைத்துளிகள் மண் மீது விழும் வேகத்தில் இந்த வித்துகள் காற்றை நோக்கி மேலே வீசப்படுகின்றன. அதில் வெளிப்படும் வேதிப்பொருள் டைமெதில் 9 டிகலால். நாம் சுவாசிக்காத வித்துகள் மீண்டும் ஈரமான மண்ணில் விழுந்து பாக்டீரிய இழைகளாக மாறிவிடுகின்றன.
ஓசோனும் காரணம்
அதேபோல மழை வருவதற்கு முன்பாகவும் ஒரு வாசனை வரும். அது ஓசோனின் வாசனை. இடி மின்னலுடன் மழை வரும்போது ஏற்படும் மின்சாரம் ஆக்சிஜன், நைட்ரஜன் மூலக்கூறுகளைப் பிளக்கும். அவை இணைந்து நைட்ரிக் ஆக்சைடாக மாறுகின்றன. இது வளிமண்டலத்தில் உள்ள மற்ற வேதிப்பொருட்களுடன் இணைந்து ஓசோனை உருவாக்குகிறது.
ஒரு பகுதியை நோக்கி வரும் புயல் மேகங்கள் இந்த ஓசோனைச் சுமந்துவருகின்றன. அது நமது நாசியை அடைவதால் மழை வருவதை முன்கூட்டியே உணர முடிகிறது.
பண்டைக்காலத்தில் மழைதான் உலகுக்கு வளம் தரும் ஒரே விஷயமாக இருந்தது. அதனால், நமது மூதாதையர் களுக்கு மழை ரொம்ப பிடித்த விஷயமாக இருந்தது. அது மரபணுக்கள் வழியாகக் கடத்தப்பட்டு, நமக்கும் மண்வாசனை பிடித்தமான விஷயமாக இருக்கிறது.